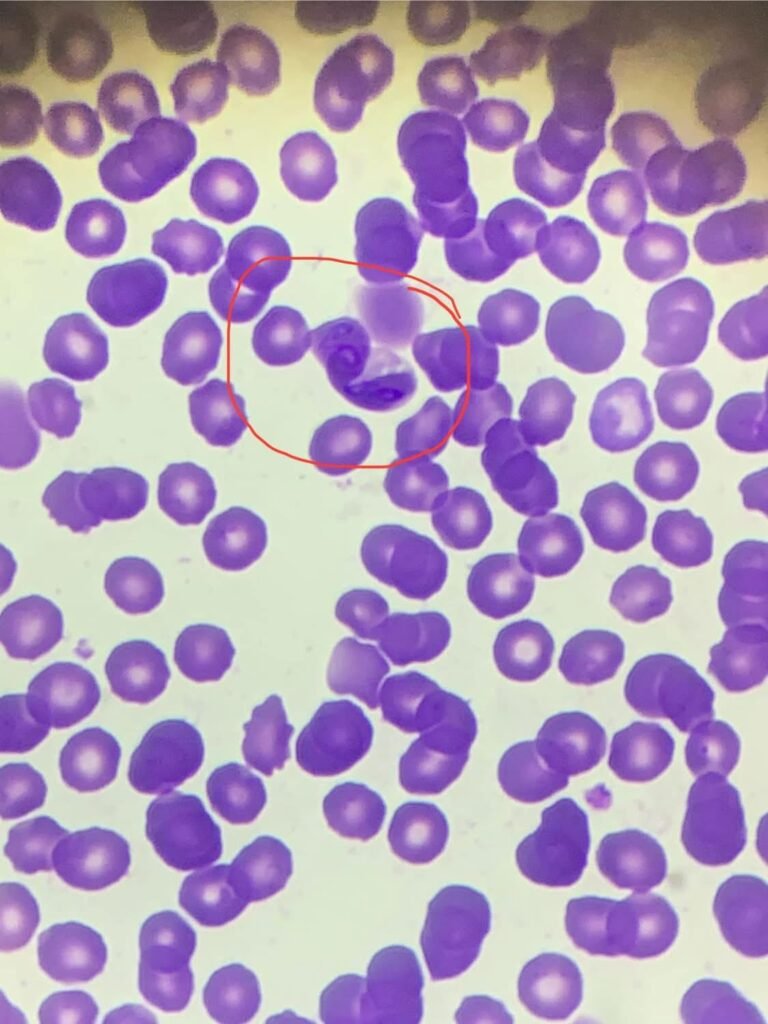
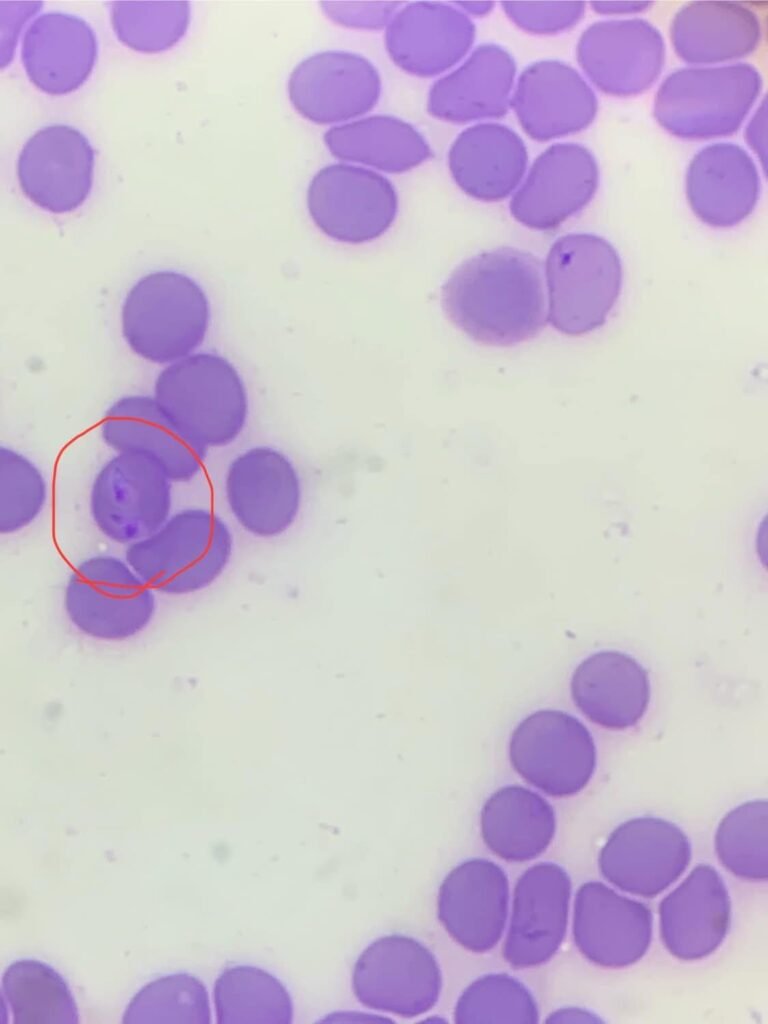

Babesioza la câini: cauze, simptome și tratament
Ce este Babesioza?
Babesioza la câine este o boală transmisă prin mușcătura de căpușă, cauzată de un hemoparazit ce infectează celulele roșii ale câinelui și determină anemie hemolitică și trombocitopenie severă.
Principalele două specii de babesii sunt:
-Babesia canis ( babesie mare )
-Babesia gibsoni ( babesie mică )
Simptome
Semnele clinice de boală sunt următoarele:
– Slăbiciune
– Letargie
– Febră
– Lipsa apetitului
– Vomă/diaree
– Anorexie
– Paloarea mucoaselor
– Urină inchisă la culoare (bilirubinurie/hemoglobinurie)
– Icter
– Anemie severă
Diagnosticare
Diagnosticul se pune pe baza anamnezei (au fost găsite căpușe pe animal), semnelor clinice și se confirmă cu teste de laborator:
– Examinare lamă hemoparaziți
– Biochimie
– Hemoleucograma
– Teste rapide
– PCR
Tratament
Tratamentul este unul complex datorită multiplelor complicații la care poate duce aceasta boală. Printre acestea se numără:
– Trombocitopenia și anemia severă
– Hiperglobulinemia
– Splenomegalia
– Coagularea intravasculară diseminată
– Anemia mediată imun
– Insuficiențe de organ (rinichi, ficat etc)
Prognosticul este rezervat și chiar nefavorabil pentru câinii netratați la timp.
Prevenție
Boala poate fi prevenită prin deparazitarea externă a câinelui tot timpul anului.
Pe piață sunt numeroase produse, sub diverse forme de prezentare și cu diverse perioade de acțiune.
Toate acestea trebuiesc administrate după ce câinele a fost cântărit, iar alegerea produsului cel mai potrivit pentru pacient se facein urma discutiei cu medicul veterinar.
Astfel pot fi prevenite diverse situații neplăcute precum:
– Alergii sau intoleranțe la substanța activă
– Vomă/ diaree postadministrare
– Supradozarea sau subdozarea produsului etc
Toate cele de mai sus sunt doar o mică descriere a acestei patologii extrem de complexă și foarte des intalnită.
Cum poate ajuta VETECOMED?
În cabinetul nostru avem tot ce este nevoie pt:
– A preîntâmpina boala (deparazitări externe sub formă de pipete/ tablete/ zgărzi/ spray)
– A diagnostica boala (laborator intern)
– A trata boala
– A recupera pacientul
Pentru orice informație și ajutor, ne bucurăm să fim contactați.
Echipa VETECOMED, din dragoste pentru blănoși!
Vă las mai jos câteva imagini microscopice cu hemoparazitul inculpat, imagini de la pacienții noștri!